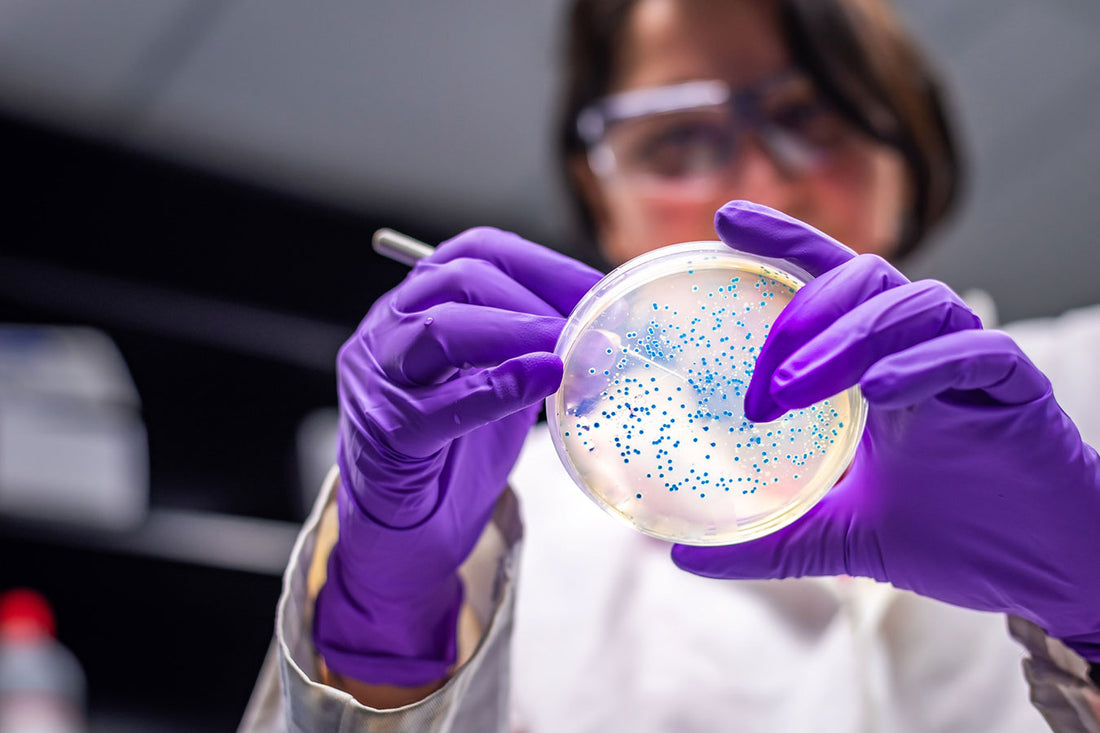

You may not be aware of this, but there may be cells other than sperm in your ejaculate. And, they might affect your fertility…
In addition to a semen analysis that examines pH, ejaculate volume, sperm concentration, total and progressive motility and sperm morphology, a microscopic examination of your sample is important for a comprehensive assessment.
What is looked at under the microscope?
Other cell populations may be present in your ejaculate such as immature (not fully developed and functioning) sperm cells, white blood cells (WBC’s) and/or degenerating epithelial cells. In most microscopic examinations of the sperm, the report will group cells into a category of cells called “round cells” and indicate if there are more than 1 million round cells.
Will more than 1 million round cells affect my fertility?
The presence of immature sperm cells may indicate a problem with spermatogenesis (sperm development). White blood cells (WBCs) are your biological army that fights off infections in your body. However, if there are greater than 1 million WBCs along with your sperm (aka pyospermia), this could be the result of an inflammation/infection in the lower genital tract. And, those WBCs could be releasing free radicals that might be harmful to your sperm and could be associated with “deficiencies in sperm function and motility.”
What can be done? Will my fertility improve if treated?
Because your microscopic examination might group together all ‘round’ cells (including immature sperm, WBC’s and epithelial cells), it’s hard to tell for sure whether the round cells are WBCs or immature sperm. Because the risk/benefit ratio of treatment is low, most fertility specialists will recommend a short course of oral antibiotics or even refer you to an andrologist/urologist if >1 Million round cells are found.
Great than 1 million round cells are a lot of non-sperm cells in the ejaculate and the potential risk to sperm if an infection is present can be avoided with a low risk, short course of antibiotics. A repeat semen analysis may be recommended to confirm a suspected infection has been treated successfully. Ultimately, it is not normal to find >1 million non sperm cells in the ejaculate and their presence may indirectly affect fertility. Because an infection might be at play, and because the risk of antibiotics is low, I still recommend treatment with antibiotics.